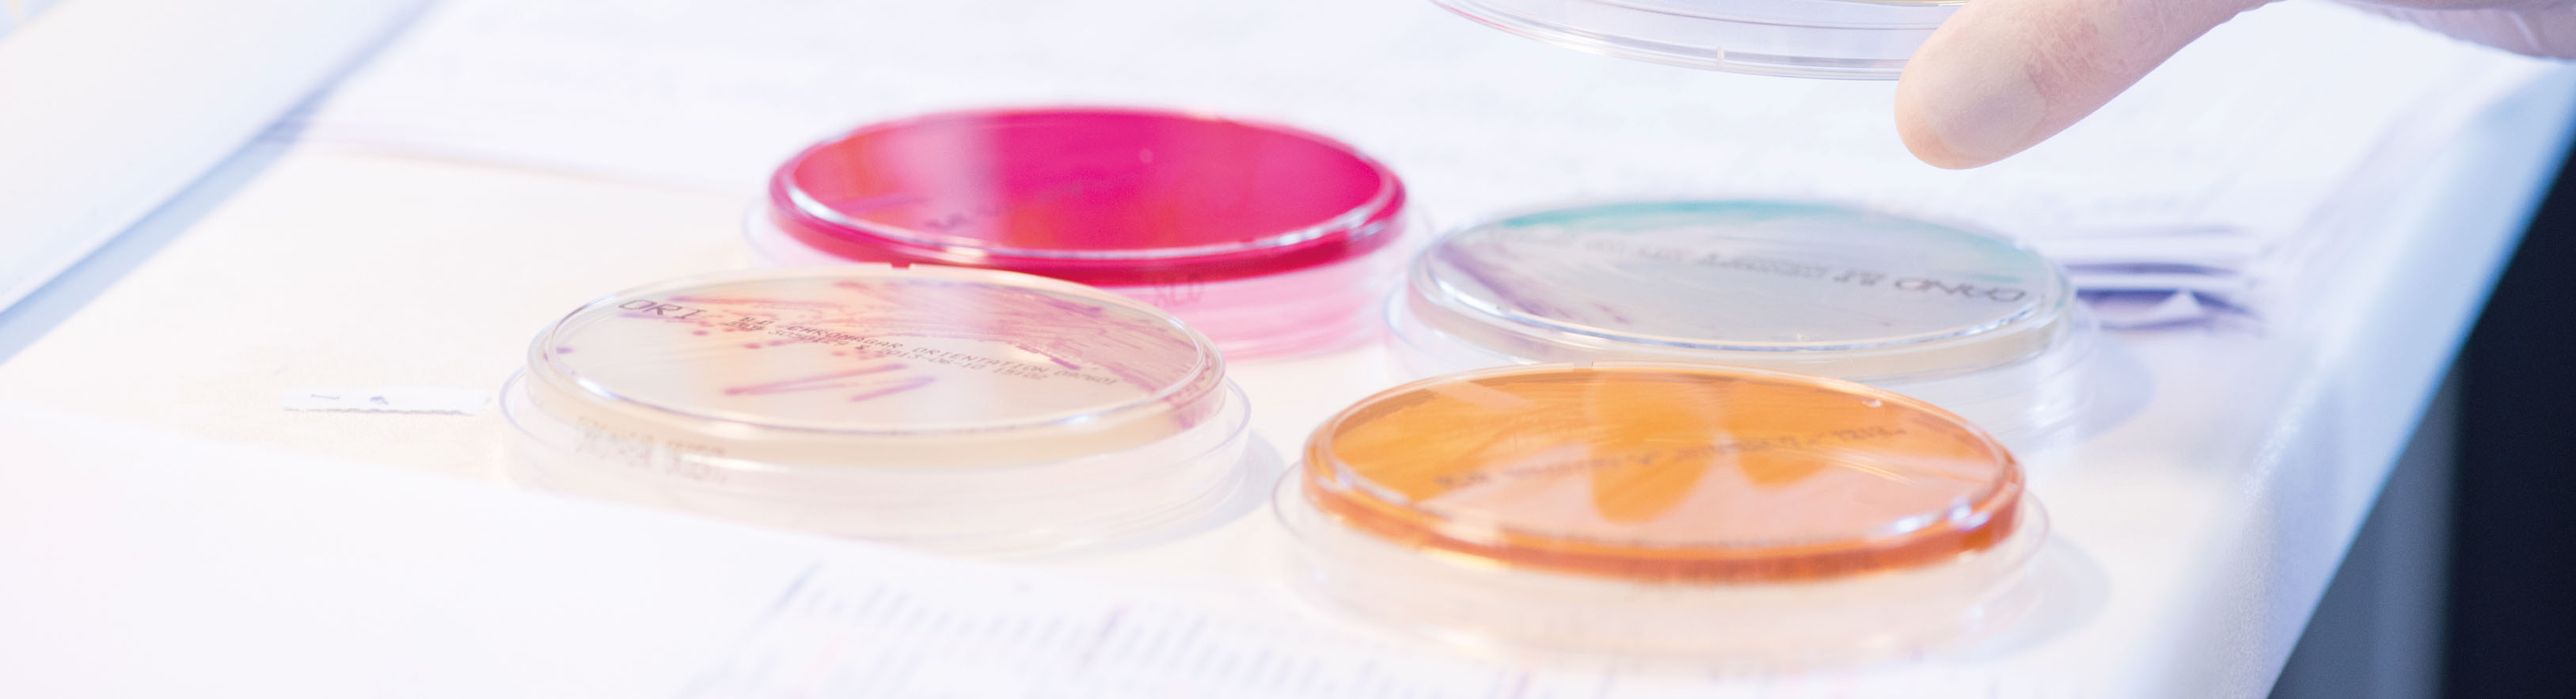
Vier Petrischalen mit verschiedenfarbigen Nährböden – rot, orange und zwei transparente – liegen auf einer weißen Fläche. Eine behandschuhte Hand hält den Deckel einer Schale. Im Hintergrund sind teilweise Dokumente zu sehen.

Facharzt (m/w/d) für die Mikrobiologie, Virologie und Infektionsepidemiologie
min. 20h/Woche
- Passau
- Vollzeit, Teilzeit
Mehr als Labor.
Die MVZ Labor Passau GmbH versorgt als das größte medizinische Facharztlabor der Region mit rund 350 Mitarbeitern zahlreiche niedergelassene Ärzte aller Fachrichtungen, Krankenhäuser und Privatpersonen. Wir zählen zu den innovativsten und technisch modernsten Facharztlaboratorien weltweit und stehen seit über 40 Jahren für qualitativ hochwertige Labormedizin. Als Teil der Limbach Gruppe, der größten inhabergeführten Laborgruppe in Deutschland, sind wir in ein bundesweites Labornetzwerk mit Spezialisten und interdisziplinären Teams eingebunden.
Ihre Aufgaben
- Fachlicher Ansprechpartner für den Bereich Mikrobiologie / Virologie und Infektionsepidemiologie
- Interpretation medizinischer Befunde und anschließende Freigabe
- Beratung der einsendenden Fachkollegen (niedergelassene Ärzte, Krankenhäuser)
- Fachübergreifende Mitarbeiter im Kollegenteam
- Ansprechpartner für die Mitarbeiter aus der Analytik
Ihr Profil
- Abgeschlossene Weiterbildung zum Facharzt für den Bereich Mikrobiologie, Virologie und Infektionsepidemiologie (m/w/d)
- Fundierte Kenntnisse der praktischen Laborroutine und/oder mikrobiologischen Diagnostik
- Strukturierte und eigenständige Arbeitsweise mit eigenverantwortlichem, wirtschaftlichem Handeln
- Qualitätsbewusstsein, Kommunikationsstärke und Leistungsbereitschaft
- Eigeninitiative und freundliches Auftreten, sowie ein hohes Maß an Verantwortungsbewusstsein
Ihre Vorteile
- Betriebliche Altersvorsorge
- Faire und leistungsgerechte Bezahlung
- Aus- und Weiterbildung
- Mitarbeiter Wlan
- Mitarbeiterprämien
- IT-Umgebung nach dem neuesten Stand der Technik
- Mitarbeiter-Überraschungen
- Parkplatz
- Vermögenswirksame Leistungen
- E-Bike Leasing
- Bäckerwagen
- Corporate Benefits
- 30 Tage Urlaub
- Mitarbeiterevents
- Krisensicherer Arbeitsplatz
Wenn wir Ihr Interesse geweckt haben, freuen wir uns über Ihre vollständige Bewerbung unter Angabe Ihrer Gehaltsvorstellung und des frühestmöglichen Eintrittstermins.

Jennifer Wimmer
Personalleiterin
Tel: +49 851 9593 103
Personalleiterin
Tel: +49 851 9593 103
